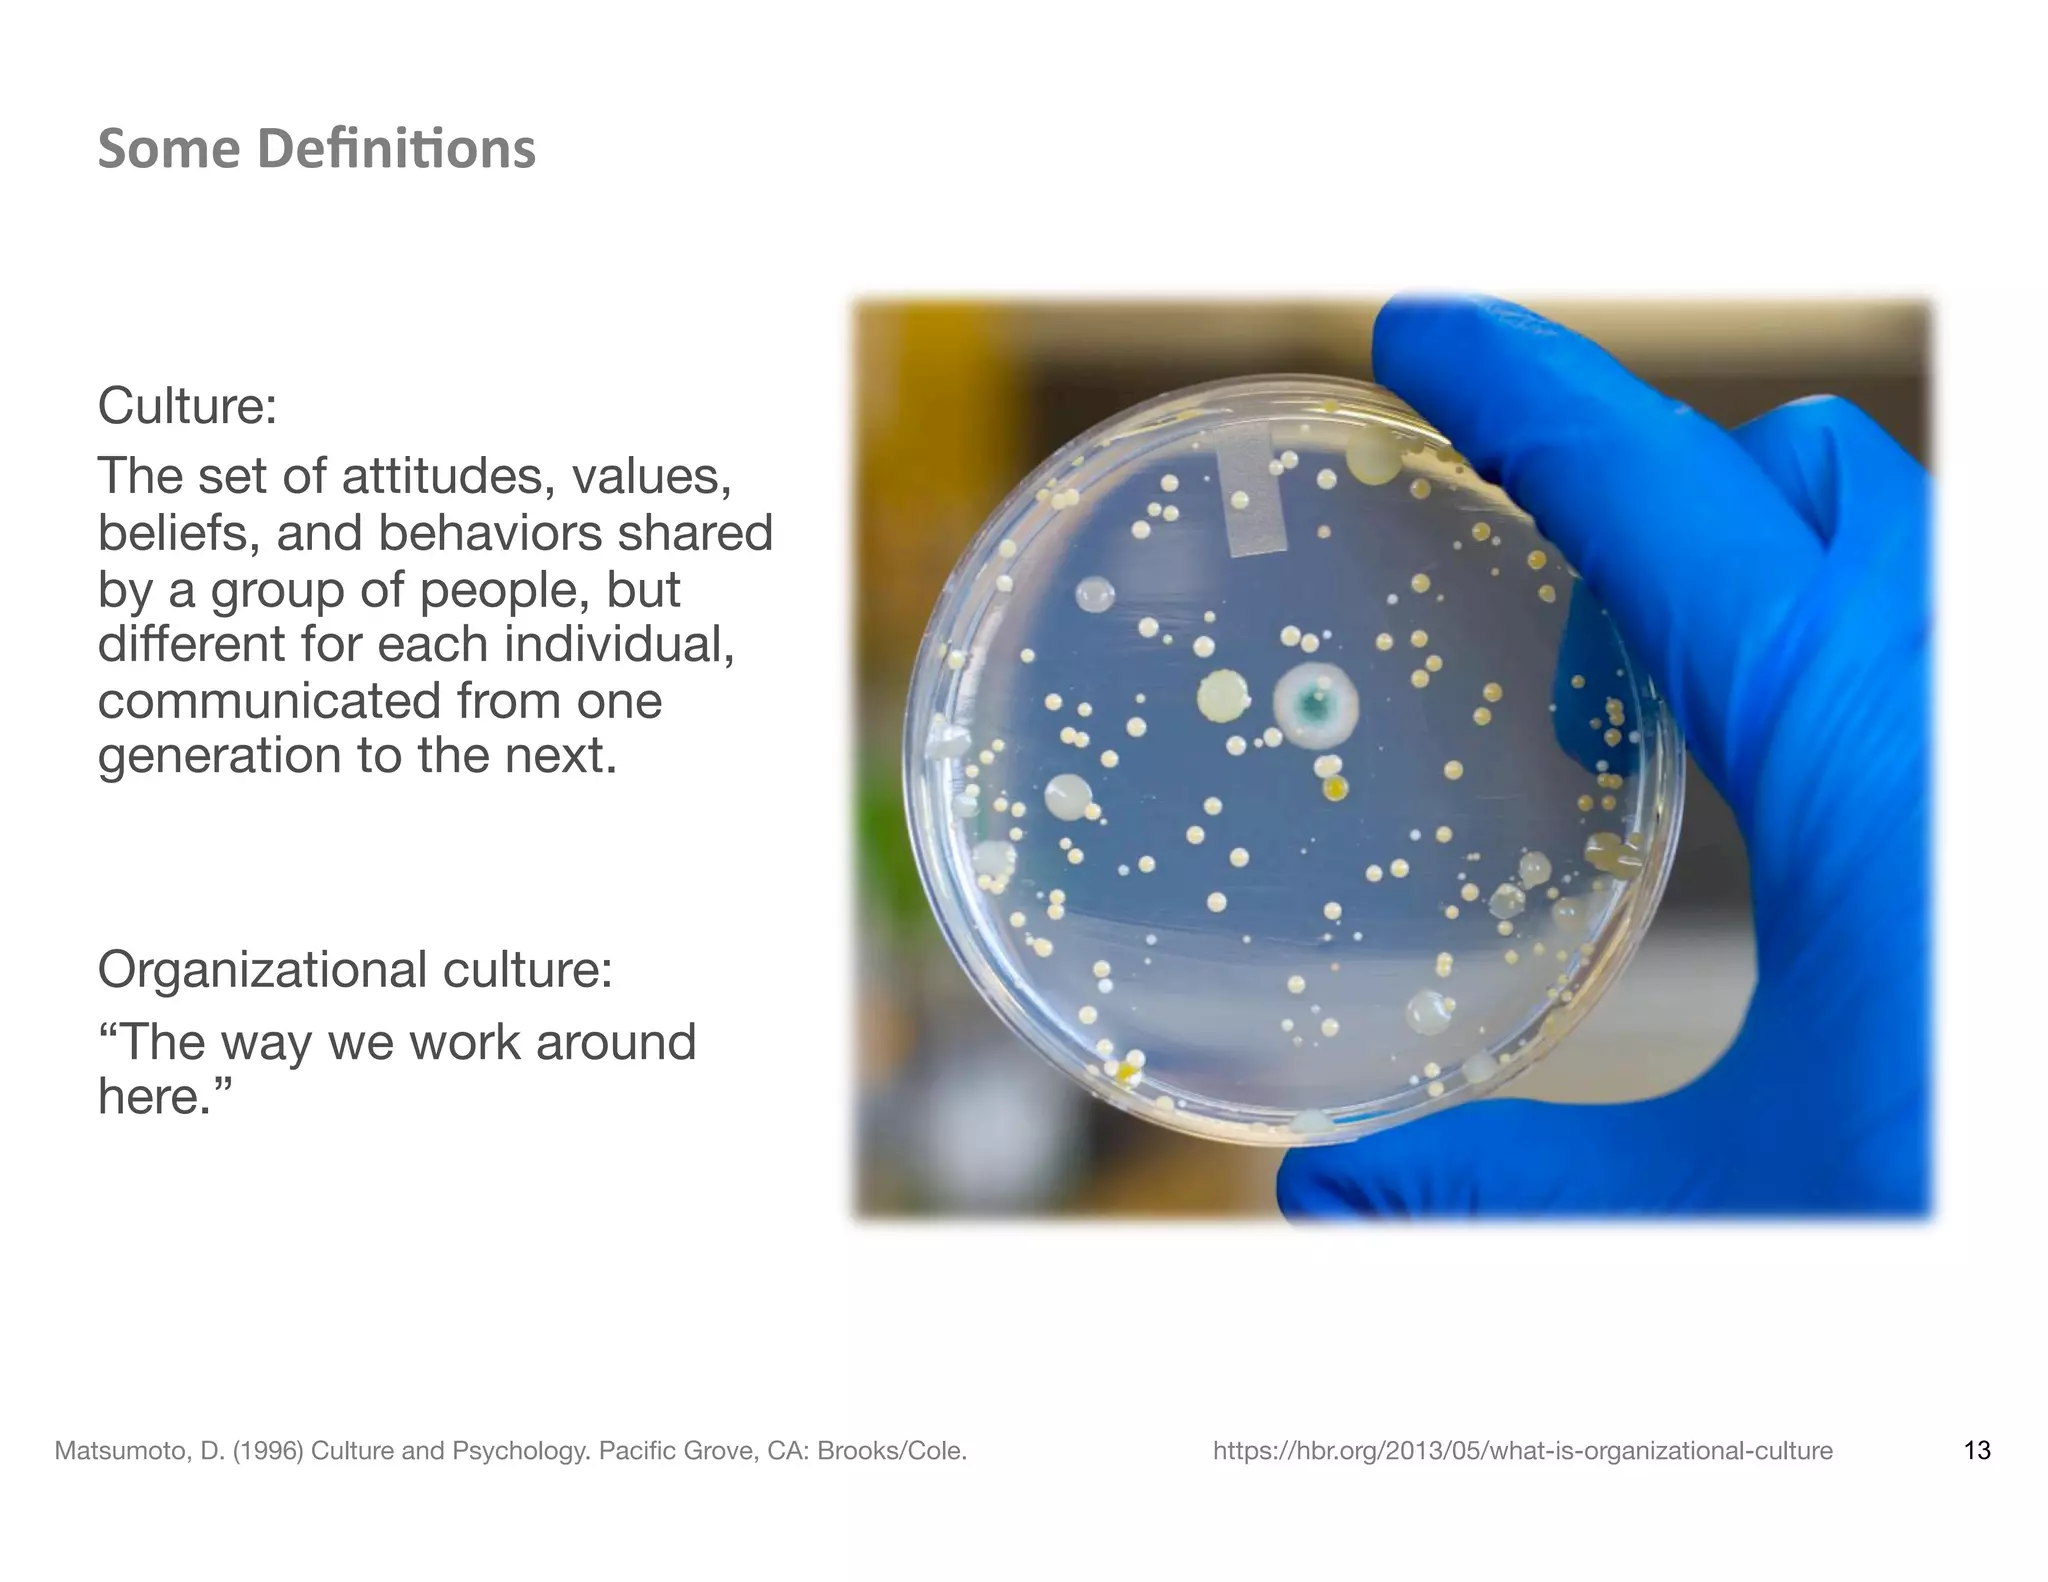
Some	
  Deﬁni8ons	
  



Culture:
The set of attitudes, values,
beliefs, and behaviors shared
by a group of people, but
diﬀerent for each individual,
communicated from one
generation to the next.


Organizational culture:
“The way we work around
here.” 

13Matsumoto, D. (1996) Culture and Psychology. Paciﬁc Grove, CA: Brooks/Cole.
 https://hbr.org/2013/05/what-is-organizational-culture

The document discusses embedding user experience (UX) processes within product development cycles. It notes that while UX is essential, most organizations don't know how to effectively integrate UX practices. The goals of the workshop are to discuss identifying UX champions, leveraging small wins to drive strategic UX approaches, and embedding the right UX activities in the product life cycle. It also discusses that "doing UX" occurs within a multi-layered environment that includes organizational culture, power structures, and other challenges.